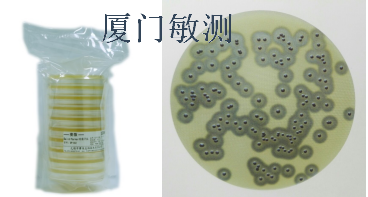

|
| | |
|
|
| | | |
|
|
 檢測認證人脈交流通訊錄
檢測認證人脈交流通訊錄
Baird-parker 瓊脂平板(B-P平板)
- 用 途:
- 用于凝固酶陽性葡萄球菌的選擇性分離培養和計數
- Baird-parker 瓊脂平板(簡稱B-P平板)用于凝固酶陽性葡萄球菌的選擇性分離培養和計數(ISO、FDA BAM、GB、SN標準)。Baird-parker 瓊脂平板已添加亞碲酸鉀卵黃增菌液,可以直接使用。
用于食品、藥品、化妝品、保健品、公共場所衛生微生物中的金黃色葡萄球菌檢測。
即用型Baird-parker 瓊脂平板培養基優點:
1、批次穩定:流水線生產,避免人工配制不穩定性;
2、原料優良:采用陸橋培養基作為原料,保證陽性菌的正常檢出;
3、無菌保證:產品在B+A潔凈車間分裝;公司為保證產品質量,已成立檢測中心,專做產品質量把控;
4、時間節省:省去常規制備步驟,為檢驗人員節省時間,提高檢測效率;
5、人員保護:避免配制過程粉塵等對人員的危害。
Baird-parker 瓊脂平板規格:10個/包 90mm
Baird-parker 瓊脂平板相關產品:
金黃色葡萄球菌顯色培養基
凍干血漿、血瓊脂平板、營養瓊脂平板、TCBS瓊脂平板、
一次性無菌接種環、接種針、無菌手套口罩、
其他微生物系列產品:菌落總數、大腸菌群、弧菌、沙門氏菌等微生物培養基、科瑪嘉顯色培養基、陸橋培養基、環凱培養基、微生物耗材。
在Baird-parker 瓊脂平板上,金黃色葡萄球菌圓形突起、光滑、濕潤,顏色呈灰
黑色至黑色,有光澤,常有淺色(非白色)的邊緣,周圍繞以不透明圈(沉淀),其外常有一清晰帶。用接種針觸及菌落時具有黃油樣黏稠感。從長期貯存的冷凍或脫水食品中分離的菌落,其黑色較典型菌落淺些,且外觀可能較粗糙,質地較干燥。
Baird-parker 瓊脂平板儲存條件:2-8℃,避光保存
更多Baird-parker 瓊脂平板(B-P平板)及微生物儀器耗材培養基等微生物檢測系列產品請來電咨詢
久久免费手机视频|
谁有免费的黄色网址|
欧美激情国产精品日韩|
国产情侣自拍小视频|
日韩精品一区二区三区电影|
中文字幕在线观看免费|
手机福利在线视频|
国产一区二区在线不卡|
国产xxxx振车|
欧美一区二区公司|
奇米影音第四色|
极品白嫩丰满美女无套|
日韩精品一卡二卡|
丝袜 亚洲 另类 欧美 重口|
亚洲一级在线播放|
国产亚洲欧美在线视频|
天天操天天操天天|
亚洲天堂av一区二区三区|
91中文字幕永久在线|
中文字幕免费在线观看视频|
国产对白在线播放|
亚洲免费视频网|
久久人人爽av|
精品伦精品一区二区三区视频密桃
|
亚洲av无码国产综合专区|
免费在线激情视频|
人人妻人人藻人人爽欧美一区|
91九色丨porny丨肉丝|
99视频精品全部免费看|
免费国产黄色片|
欧美成人综合色|
艳母动漫在线看|
人成网站在线观看|
久久精品国产亚洲av麻豆色欲|
翔田千里88av中文字幕|
国产wwwwwww|
天堂av在线8|
男人的天堂久久久|
日韩专区第一页|
动漫精品一区一码二码三码四码|
黄色一级视频播放|
美女又黄又免费的视频|
中文字幕在线观看免费视频|
日韩成人手机在线|
人妻少妇精品视频一区二区三区|
中文字幕在线一|
激情 小说 亚洲 图片: 伦|
来吧亚洲综合网|
色偷偷在线观看|
欧美激情黑白配|
北条麻妃69av|
老司机成人免费视频|
成人免费视频国产免费麻豆|
精品深夜av无码一区二区老年|
欧美狂野激情性xxxx在线观|
中国av免费看|
性欧美8khd高清极品|
日韩男人的天堂|
日本熟妇人妻xxxxx|
精品少妇一区二区三区密爱|
亚洲欧洲国产综合|
中日韩av在线|
精品视频在线观看免费|
国产精品宾馆在线精品酒店|
免费成年人视频在线观看|
三大队在线观看|
亚洲一区二区人妻|
欧美亚韩一区二区三区|
性chinese极品按摩|
欧美成人精品免费|
精品无码一区二区三区蜜臀|
成年人小视频在线观看|
av av片在线看|
亚洲欧美偷拍一区|
欧美精品成人久久|
538在线视频观看|
六月婷婷激情综合|
久久福利免费视频|
91网站免费视频|
无码人妻aⅴ一区二区三区玉蒲团|
中国女人真人一级毛片|
在线免费观看毛片|
午夜剧场高清版免费观看|
国产白丝袜美女久久久久|
久久久精品少妇|
色欲av无码一区二区三区|
天天操天天操天天干|
国产精品无码免费播放|
人人妻人人爽人人澡人人精品|
国产在线视频三区|
自拍偷拍21p|
日av中文字幕|
欧美黄色免费影院|
色欲色香天天天综合网www|
一区二区视频免费看|
日本猛少妇色xxxxx免费网站|
国产精品九九视频|
日本精品一二三区|
又黄又爽又色的视频|
国产刺激高潮av|
国产77777|
丰满人妻av一区二区三区|
国产精品久久久久久久一区二区|
国产精品sm调教免费专区|
亚洲免费在线视频观看|
狠狠人妻久久久久久|
亚洲黄色激情视频|
日韩中文字幕在线观看视频|
国产精品100|
无码人妻久久一区二区三区|
欧美一区二区三区不卡视频|
亚洲中文一区二区|
中文字幕人成人乱码亚洲电影|
人人妻人人爽人人澡人人精品|
91视频久久久|
97精品人妻一区二区三区|
国产精品国产三级国产普通话对白|
中文字幕日本人妻久久久免费|
一区两区小视频|
国产精品高潮呻吟AV无码|
国产成a人亚洲精v品无码|
精品国产av一区二区|
欧美特黄一级视频|
国产精品99久久久精品无码|
午夜免费福利影院|
波多野在线播放|
免费中文字幕在线|
成人区一区二区|
国产综合免费视频|
久久精品亚洲天堂|
可以在线观看av的网站|
中文字幕第99页|
www.成人在线观看|
国产性猛交96|
色噜噜噜噜噜噜|
日本福利视频在线观看|
免费日韩视频在线观看|
日韩不卡的av|
黄色一级视频免费看|
国产精品国产一区二区三区四区
|
大地资源二中文在线影视观看|
国产一区二区三区四区在线|
午夜啪啪免费视频|
91视频 -- 69xx|
中文字幕55页|
中文字幕久久久久|
姝姝窝人体www聚色窝|
欧美图片一区二区|
黄色影视在线观看|
成人中文字幕av|
在线观看国产亚洲|
精品人妻一区二区三区浪潮在线|
亚洲免费观看在线|
一区二区国产精品精华液|
黄色免费观看视频网站|
久草成人在线视频|
国产乱码精品一区二区三区精东|
95视频在线观看|
自拍偷拍视频在线|
蜜桃免费在线视频|
九九热最新视频|
av免费观看不卡|
午夜啪啪福利视频|
婷婷激情5月天|
97人妻人人澡人人爽人人精品|
亚洲av无码专区在线播放中文|
午夜免费激情视频|
欧美日韩中文不卡|
国产精品乱码久久久|
一本色道久久综合亚洲精品图片|
日本福利视频在线观看|
久久久久久久久久久97|
国产高清免费av|
永久免费观看片现看|
www黄色在线|
欧美成人一区二区视频|
深田咏美中文字幕|
国产真实老熟女无套内射|
日本中文字幕网|
亚洲人成色777777老人头|
波多野结衣家庭教师|
欧美激情第3页|
www.久久久久久|
欧美日韩黄色网|
激情五月婷婷在线|
www.久久成人|
tube国产麻豆|
久操免费在线视频|
国产伦精品一区二区三区妓女下载
|
亚洲AV无码国产成人久久|
人妻少妇精品无码专区二区|
国产一级免费视频|
97人妻精品一区二区免费|
国产精品亚洲二区在线观看|
国产理论视频在线观看|
黄色精品视频在线观看|
九九九免费视频|
欧美在线观看成人|
色呦色呦色精品|
中文久久久久久|
美国一级片在线观看|
麻豆changesxxx国产|
中文字幕 欧美激情|
一级黄色大片免费看|
欧美狂野激情性xxxx在线观|
国产成人无码一区二区在线播放|
欧美夫妇交换xxx|
色哟哟精品视频|
亚洲精品久久久久久久久久久久久久
|
国产又粗又长又大视频|
久久久精品少妇|
日韩美女黄色片|
亚洲天堂久久新|
欧美人妻精品一区二区免费看|
天堂在线观看av|
干日本少妇首页|
97中文字幕在线|
国产精品传媒在线观看|
男人操女人的视频网站|
国产一区二区99|
18啪啪污污免费网站|
国产在线视频第一页|
国产成人av一区二区三区不卡|
黄色一级片免费播放|
亚洲国产第一区|
欧美日韩中文字幕在线观看|
黄色一级片在线|
日韩中文字幕高清|
免费黄视频在线观看|
哪个网站能看毛片|
欧美一级视频免费|
无码人妻丰满熟妇区毛片18
|
久久视频免费在线观看|
老牛影视av老牛影视av|
免费在线看黄网址|
久久久免费看片|
亚洲大片免费观看|
无码人妻精品一区二区三区99v|
国产永久免费视频|
阿v天堂2017|
欧美丰满熟妇bbb久久久|
热久久久久久久久|
三级网站在线免费观看|
亚洲GV成人无码久久精品|
国产探花在线免费观看|
99久久精品无免国产免费|
国产精品无码一区二区在线|
特种兵之深入敌后|
久久久精品视频免费|
国产日韩欧美在线观看视频|
国产精品视频久久久久久|
自慰无码一区二区三区|
亚洲乱妇老熟女爽到高潮的片|
免费人成年激情视频在线观看|
中国1级黄色片|
91激情在线观看|
超碰影院在线观看|
精品人伦一区二区三电影|
伊人久久中文字幕|
情侣黄网站免费看|
微拍福利一区二区|
97人妻精品一区二区三区视频|
成人小视频在线看|
日韩女同一区二区三区|
国产精品无码专区av免费播放|
欧美牲交a欧美牲交aⅴ免费下载|
中文字幕在线免费看线人|
国产又黄又猛又粗又爽|
欧美 日本 亚洲|
巨胸大乳www视频免费观看|
wwwwww在线观看|
久久午夜夜伦鲁鲁一区二区|
亚洲自拍偷拍图|
性猛交xxxx乱大交孕妇印度|
91亚洲精品久久久蜜桃借种|
亚洲最大的黄色网址|
亚洲色偷精品一区二区三区|
天天爽夜夜爽夜夜爽精品|
69堂免费视频|
亚洲精品自拍视频在线观看|
亚洲欧美另类视频|
天天操夜夜操视频|
日本999视频|
在线观看xxx|
91黄色免费视频|
国产人妖一区二区|
国产一级在线免费观看|
欧美精品99久久|
国产成人av免费在线观看|
成人做爰69片免费|
亚洲一区二区激情|
九九热精品免费视频|
heyzo亚洲|
久久精品一区二区三区四区五区|
男人女人拔萝卜视频|
在线视频你懂得|
久久精品国产亚洲av麻豆色欲|
中文字幕无码精品亚洲资源网久久|
老牛影视av老牛影视av|
欧美一级一区二区三区|
wwwwww在线观看|
成人免费看片98|
天天影视综合色|
中文字幕在线中文|
成人欧美一区二区三区黑人一
|
免费中文字幕在线|
无码熟妇人妻av|
国模大尺度视频|
国产又大又黑又粗|
中文字幕激情小说|
天天干天天曰天天操|
日韩av片在线看|
中国丰满熟妇xxxx性|
久久久精品视频免费观看|
亚洲国产欧美视频|
少妇性l交大片7724com|
国产欧美第一页|
中文字幕电影av|
波多野在线播放|
国产精品嫩草av|
免费看三级黄色片|
神马久久久久久久久久|
国产视频在线一区|
亚洲中文一区二区三区|
中文字幕在线日本|
九九热在线免费观看|
久久久久久久黄色|
青青草偷拍视频|
潘金莲激情呻吟欲求不满视频|
av片中文字幕|
人人爽人人av|
中文字幕无码不卡免费视频|
久色视频在线播放|
国产中文字幕视频在线观看|
国产精品久久国产|
国产情侣第一页|
久青草视频在线播放|
久久av综合网|
国产精品成人久久电影|
亚洲国产精品无码观看久久|
国产xxxx振车|
色欲色香天天天综合网www|
日韩亚洲欧美一区二区|
青青视频免费在线|
精品无码国产一区二区三区av|
日韩a级黄色片|
国产96在线 | 亚洲|
欧美 日本 亚洲|
中文字幕第36页|
午夜免费看视频|
九九视频免费观看|
香蕉视频一区二区|
日韩精品在线免费视频|
综合久久中文字幕|
国产精品久久欧美久久一区|
国产成人精品一区二三区四区五区|
国产毛片在线视频|
国产91美女视频|
又色又爽又高潮免费视频国产|
992kp快乐看片永久免费网址|
亚洲一级片网站|
久青草视频在线观看|
潘金莲一级淫片aaaaaa播放|
涩涩视频在线观看|
成人精品在线播放|
国产a级片视频|
精品无码人妻一区二区免费蜜桃|
午夜国产小视频|
www.日本少妇|
999在线观看|
久久久精品福利|
国产精品无码一区二区桃花视频|
六月婷婷综合网|
人妻丰满熟妇aⅴ无码|
性生交大片免费全黄|
福利视频免费在线观看|
亚洲国产精品三区|
伊人久久综合视频|
国产高清在线观看视频|
中国黄色片视频|
日本免费网站视频|
国产无限制自拍|
日韩av影视大全|
中文精品久久久久人妻不卡|
秋霞网一区二区|
老司机午夜福利视频|
国产一级生活片|
一级全黄裸体免费视频|
欧美一区二区黄片|
wwwwxxxx国产|
毛片在线视频观看|
色wwwwww|
日韩a级片在线观看|
黄色av电影网站|
亚洲精品久久久久久国|
91好吊色国产欧美日韩在线|
九九视频免费在线观看|
国产精品高潮呻吟久久久|
91九色蝌蚪porny|
麻豆映画在线观看|
 檢測認證人脈交流通訊錄
檢測認證人脈交流通訊錄